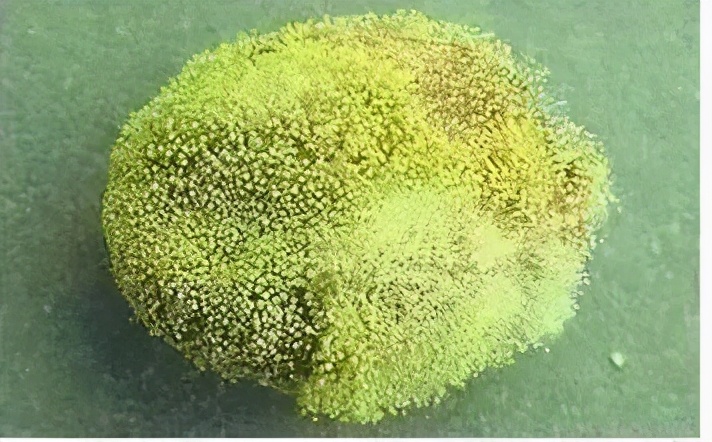
五步解决黄曲霉毒素风险|三饮茶会遇见金花藏茶

黄曲霉图片金花

茶课| 三招让你辨识金花与黄曲霉
图片尺寸640x476
金花普洱普洱金花怎么区分是金花还是黄曲霉
图片尺寸2048x1536
哪位大神知道这是金花还是黄曲霉菌
图片尺寸654x457
普洱茶的金花是不是致癌的黄曲霉素
图片尺寸640x441
注意普洱茶上的黄点不一定是金花很可能是剧毒黄曲霉
图片尺寸600x457
如何分辨发霉,金花,白霜?
图片尺寸580x435
五步解决黄曲霉毒素风险|三饮茶会遇见金花藏茶
图片尺寸712x442
今天小匠就给各位茶友教几招如何辨别"金花"和"黄曲霉素"!
图片尺寸1156x1086
注意金花菌与黄曲霉菌
图片尺寸750x750
实在分不清这是金花还是黄曲霉 不太敢喝.
图片尺寸768x1024
如何分辨茯砖茶上的"金花"和"霉变" 黄曲霉外观也呈黄色片状分布,在
图片尺寸2094x1280
茶课| 三招让你辨识金花与黄曲霉
图片尺寸1080x810
哪位大神知道这是金花还是黄曲霉菌
图片尺寸744x531
如何区分普洱茶的金花和黄曲霉
图片尺寸605x375
黑茶金花黄曲霉三招就能辨别
图片尺寸640x483
注意金花菌与黄曲霉菌
图片尺寸750x479
请问大家这个是金花还是黄曲霉素
图片尺寸872x496
伏茶里的金花是黄曲霉素吗_金花茯茶里的是什么菌
图片尺寸550x365
黑茶的金花菌会不会被100沸水杀死
图片尺寸640x369
买茶从此不上当:看图片认识和了解黄曲霉(素)和金花(冠突散囊菌)的
图片尺寸600x399